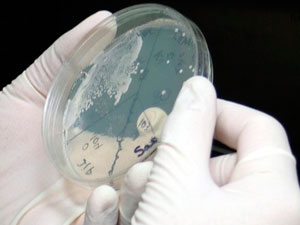
лечиться от молочницы

Диагностирование и лечение молочницы.
Генитальный кандидоз (в народе - молочница) – это грибковое заболевание, поражающее наружные и внутренние половые органы, встречающееся преимущественно у женщин, реже у мужчин. Название этой болезни происходит от названия грибка Candida, который является ее возбудителем. Восемь женщин из десяти хоть раз в жизни сталкивались с молочницей, а у 20% заболевание носит хронический характер.
 Молочницу можно распознать по ряду симптомов: творожистые выделения, имеющие характерный «кисломолочный запах», небольшой отек пораженной области, творожистый налет на половых органах, зуд и жжение, дискомфорт во время полового акта, болезненные мочеиспускания.
Молочницу можно распознать по ряду симптомов: творожистые выделения, имеющие характерный «кисломолочный запах», небольшой отек пораженной области, творожистый налет на половых органах, зуд и жжение, дискомфорт во время полового акта, болезненные мочеиспускания.
Хотя кандидоз и относится к заболеваниям, передающимся половым путем, он встречается даже у маленьких детей. Сам по себе грибок Candida– это часть влагалищной микрофлоры и не представляет опасности, если не начнет активно разрастаться. Толчком к этому может послужить длительный прием антибиотиков, резкое переохлаждение, снижение иммунитета (например, после ОРВ), плохая гигиена интимных мест, половые инфекции. Из-за гормональных колебаний молочница часто обостряется во время беременности.
Не занимайтесь самостоятельно лечением молочницы. Даже разрекламированные по телевизору препараты против молочницы надо применять ТОЛЬКО ПО РЕКОМЕНДАЦИЯМ ЛЕЧЕЩАГО ВРАЧА.
Существует любопытная закономерность: чем более распространенной является болезнь, тем реже с ней обращаются к врачу. Заметив у себя симптомы молочницы, женщины почему-то не идут в клинику, стараясь вылечить молочницу дома. Но народные методы лечения молочницы и разрекламированные препараты устраняют лишь симптомы, оставляя основную проблему нерешенной.
Назначать лечение при кандидозе может только дипломированный врач венеролог или гинеколог. Медицинский центр «Твой доктор» предлагает полную диагностику и лечение молочницы. Для уточнения диагноза и исключения других заболеваний, необходимо пройти ряд лабораторных исследований. Обычно их всего два: микроскопия вагинального мазка и бактериологический посев микрофлоры. Все анализы сдаются и проводятся в нашей собственной лаборатории, поэтому результаты врач получит сразу после их обработки, и сможет назначить исключительно индивидуальный курс лечения, к которому Вы должны приступить незамедлительно.
Молочницу лечат противогрибковыми и противомикробными препаратами. Наилучший результат дает комбинация местного (свечи, мази) и внутреннего применения лекарств от кандидоза. Часто молочница – это сигнал о снижении иммунитета. У нас вы сможете пройду консультацию у смежных специалистов. Врачи, к основному лечению, назначают препараты для восстановления иммунитета.
Молочницу лечат противогрибковыми и противомикробными препаратами. Наилучший результат дает комбинация местного (свечи, мази) и внутреннего применения лекарств от кандидоза. Часто молочница – это сигнал о снижении иммунитета. У нас вы сможете пройду консультацию у смежных специалистов. Врачи, к основному лечению, назначают препараты для восстановления иммунитета.
По окончанию лечения рекомендуется прокипятить все предметы, на которых мог остаться грибок: нижнее и постельное белье, полотенца и т.д.
Цены на лечение молочницы вы можете посмотреть в соответствующем разделе.
{mylink}
Наши доктора на ТВ
Медицинский центр "Твой доктор" в Митино и филиал на Таганке.
В любой день можно сдать анализы. Помимо лабораторных исследований вы можете пройти без очередей все процедуры и исследования инструментальной диагностики: УЗИ, ЭКГ, рентген, гастроскопия.
У нас в процедурном кабинете можно сдать анализы, сделать перевязку, налжить гипс, проверить давление и прочее, что соответстует стандарту медицинского обслуживания
Клиника в Митино открыла свои двери много лет назад для всех, кто заботится о своем здоровье и ценит комфорт медицинского обслуживания.
Основная задача клиники – помочь устранить причины заболевания, вылечить болезнь. Мы знаем, что когда мы сможем помочь Вам, это будет самой лучшей рекламой нашей клиники. Медицинский центр имеет дневной стационар.
.jpg)






















